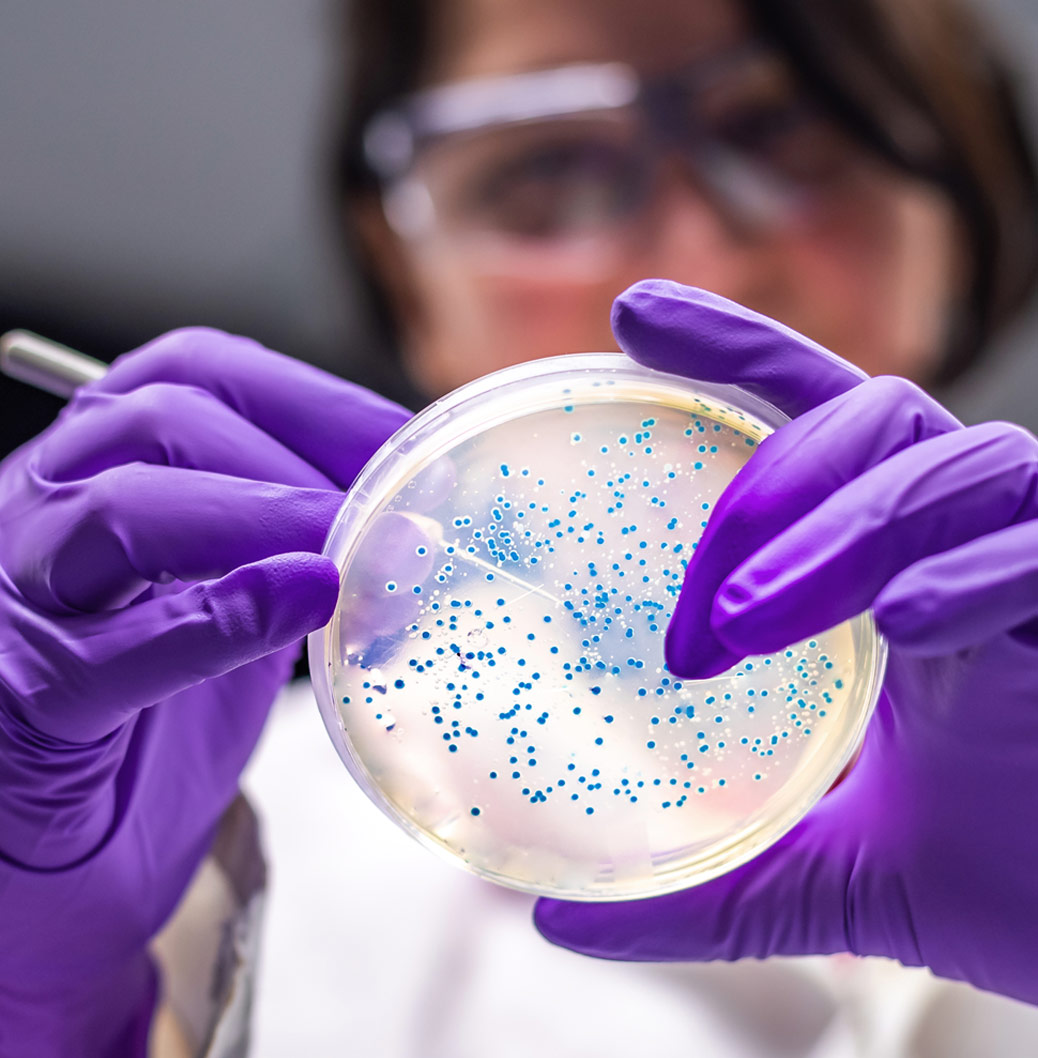

Viatris Lietuvoje
Mūsų komanda yra pasiryžusi pagerinti pacientų sveikatą visuose jų gyvenimo etapuose.
Priklausome Vaistų gamintojų asociacijai Lietuvoje, kurios tikslai yra artimi mūsų misijai: skatinti kuo didesnį vaistinių preparatų prieinamumą.
Džiaugiamės galėdami pacientams Lietuvoje pasiūlyti platų vaistinių preparatų asortimentą pagrindinėse terapinėse srityse: